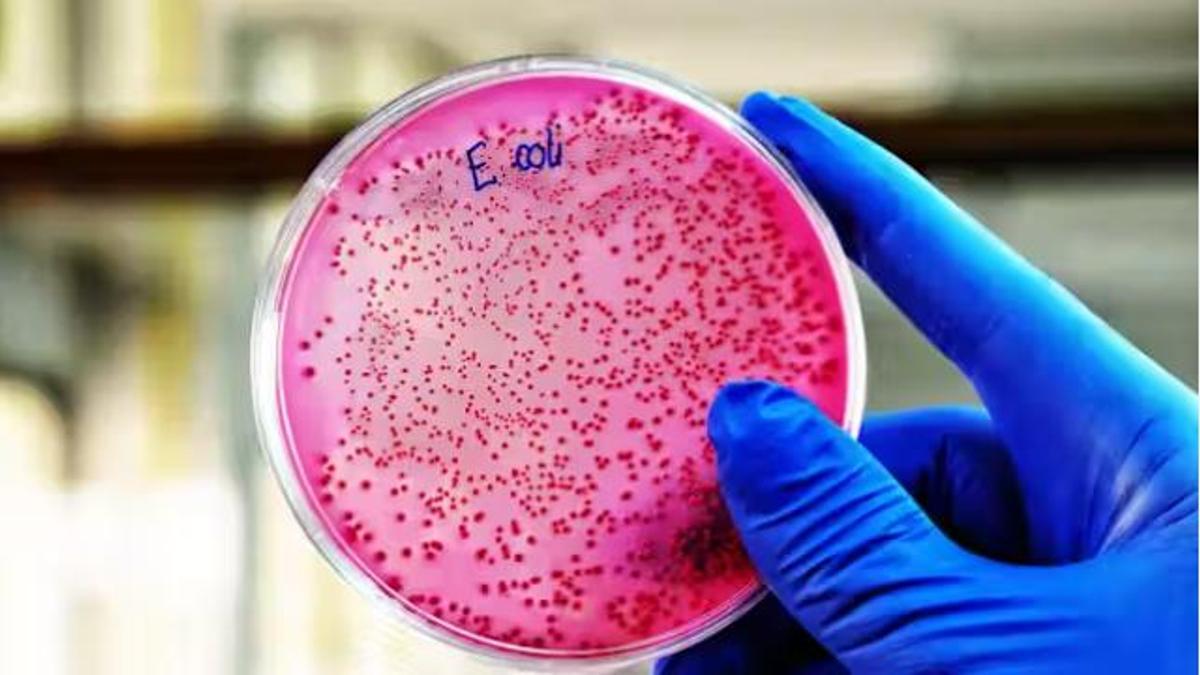

Un estudio asocia el cáncer colorrectal en personas jóvenes con una infección bacteriana en la infancia
La exposición a la toxina colibactina, presente en algunas cepas de una bacteria frecuente en el intestino y el colon (‘Escherichia coli’), puede desencadenar alteraciones en el ADN de las células del colon y dejar huellas frecuentes en pacientes con aparición temprana de la enfermedad: «Es un posible biomarcador»
Los médicos se preguntan por qué está aumentando el cáncer en las personas jóvenes
El cáncer es una enfermedad asociada al envejecimiento: cuantos más años tienen las células, más posibilidades hay de que fallen sus mecanismos de replicación. En los últimos años, sin embargo, los médicos han empezado a constatar un aumento de diagnósticos en personas jóvenes. Y no solo es una sensación cualitativa en las consultas. Diversos estudios, el último recogido por The Lancet Oncology hace unos meses, constatan el crecimiento de casos en menores de 50 años de muchos países occidentales. España de momento se salva de esta tendencia, aunque muchos médicos asumen que es cuestión de tiempo que los diagnósticos terminen escalando. Por qué ocurre es una de las grandes preguntas que se hacen los investigadores. Muchos jóvenes no tienen antecedentes familiares y presentan pocos factores de riesgo conocidos.
Un equipo internacional de científicos ha dado con una clave que puede contribuir a descifrar el misterio. El trabajo, publicado este jueves en la revista Nature y liderado por la Universidad de California en San Diego con la participación de un investigador español del Centro Nacional de Investigaciones Oncológicas (CNIO), asocia la aparición temprana de estos cánceres, entre otros factores, con la exposición durante la niñez a una toxina bacteriana, llamada colibactina, que tiene la capacidad de alterar el ADN de las células del colon. Esta colibactina es producida por algunas cepas de Escherichia coli, una de las múltiples bacterias que pueblan el colon y el recto, y ahora es sospechosa por desempeñar un papel en el desarrollo de cáncer colorrectal.
Los autores analizaron 981 genomas de pacientes con cáncer colorrectal de 11 países. “Los resultados muestran que la colibactina deja tras de sí patrones específicos de mutaciones del ADN, patrones identificables como auténticas ‘firmas mutacionales’ que son 3,3 veces más frecuentes en los adultos menores de 40 años que en los diagnosticados después de los 70”, apunta el CNIO en una nota de prensa. Estas huellas de la colibactina tienen mucha más prevalencia en países con alta incidencia de cáncer colorrectal entre jóvenes.
Ludmil Alexandrov, de la Universidad de California en San Diego y autor principal del estudio, asegura que los hallazgos apuntan a que “la exposición a la colibactina en etapas tempranas de la vida promueve el cáncer colorrectal de aparición precoz”. O sea, que las bacterias productoras de colibactina, al colonizar el colon de niños y niñas, iniciarían cambios moleculares que prepararían el terreno para el cáncer colorrectal, aunque los investigadores puntualizan que es necesario seguir avanzando para “establecer la causalidad”.
Según los resultados, los efectos nocivos de la colibactina empiezan pronto. Las mutaciones asociadas a la colibactina surgen en una fase temprana del desarrollo tumoral, lo que coincide con estudios previos que muestran que tales mutaciones se producen en los primeros 10 años de vida, según el CNIO. “Si alguien adquiere una de estas mutaciones impulsoras a los 10 años”, explica Alexandrov, “podría adelantarse décadas en el desarrollo del cáncer colorrectal y padecerlo a los 40 años en lugar de a los 60”.
Un nuevo biomarcador
Para Isabel Portillo, investigadora del grupo Biomarcadores en Cáncer del Instituto de Investigación Sanitaria Biobizkaia, este trabajo avanza en el conocimiento sobre “la génesis y desarrollo del cáncer” y aporta “una nueva evidencia de un posible marcador asociado al colorrectal”. Pero también es un “reflejo de las incertidumbres y la necesidad de realizar estudios que corroboren y evidencien el papel del microbioma y su posible efecto beneficioso” y todavía se requieren “más investigaciones” para perfilar esta asociación. La científica, en declaraciones a Science Media Centre , echa de menos que “no se hable de otros factores de riesgo medioambientales y de alimentación o hábitos saludables que también están relacionados”.
La cautela predomina entre los expertos ante las conclusiones. “El artículo muestra que las firmas mutacionales en el cáncer colorrectal varían entre países, lo que supone una buena evidencia de las diferencias regionales en la exposición ambiental. Sin embargo, la observación de que las firmas de colibactina son más comunes en los cánceres colorrectales jóvenes no es una prueba concluyente de que el aumento de la exposición a la colibactina sea una causa importante del reciente aumento del cáncer colorrectal en las generaciones sucesivas nacidas desde la década de 1950”, apunta Julian Peto, catedrático de Epidemiología de la London School of Hygiene & Tropical Medicine (Reino Unido).
Esta línea de investigación despierta muchas preguntas que todavía no tienen respuesta, según los autores: ¿Cómo se exponen los niños a las bacterias productoras de colibactina y qué se puede hacer para prevenir o mitigar esa exposición? ¿Hay dietas o estilos de vida más propicios a la producción de colibactina? ¿Cómo pueden las personas averiguar si ya tienen estas mutaciones? “Ya se estudia si el uso de probióticos podría eliminar de forma segura las cepas bacterianas nocivas, y se están desarrollando pruebas de detección precoz que analicen muestras de heces en busca de mutaciones relacionadas con la colibactina”, apunta el CNIO.
Un hallazgo inesperado
Los científicos llegaron hasta aquí sin haberlo planeado. “Cuando iniciamos este proyecto no pensábamos centrarnos en el cáncer colorrectal de aparición temprana”, afirma Marcos Díaz Gay, jefe del nuevo de Grupo de Genómica Digital del CNIO. “Nuestro objetivo –prosigue– era examinar los patrones mundiales de cáncer colorrectal para entender por qué algunos países tienen tasas mucho más altas que otros. Pero a medida que profundizábamos en los datos, uno de los hallazgos más interesantes y llamativos fue la frecuencia con la que las mutaciones relacionadas con la colibactina aparecían en los casos de aparición temprana”.
El trabajo, aunque todavía es básico, promueve una forma de pensar el cáncer mucho más amplia, teniendo en cuenta que no solo influye lo que ocurre en la edad adulta sino también en la etapa inicial de la vida, mucho antes del diagnóstico Además, dicen los investigadores, evidencia el recorrido que tiene el estudio de las huellas genéticas para identificar posibles carcinógenos hasta ahora desconocidos. Como este caso.
El estudio forma parte del proyecto Mutographs of Cancer – Cancer Research UK Grand Challenge Project, una colaboración de la Universidad de California en San Diego, el Wellcome Sanger Institute y la Agencia Internacional para la Investigación sobre el Cáncer que busca patrones de mutaciones causadas por agentes ambientales, como la radiación UV, las toxinas bacterianas, el tabaco y el alcohol.